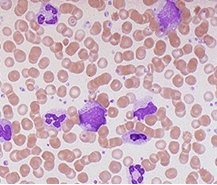
급성 백혈병의 FAB 분류 vs WHO 분류 비교 분석: 진단 체계의 진화와 임상적 의의

1. FAB 분류 체계의 역사와 주요 특징
FAB(French-American-British) 분류는 1976년 도입된 형태학적 분류법으로, 골수와 말초혈액 도말 검사에서 관찰되는 세포 형태와 세포화학적 염색을 기반으로 AML을 M0부터 M7까지 8가지 아형으로 구분합니다.
▶ FAB 분류의 핵심 아형
FAB 유형진단 기준임상적 특징
| M0 | 미분화형 | MPO(미엘로퍼옥시다아제) 음성, 면역표현형 필수 |
| M3 | 급성 전골수구성 백혈병 | t(15;17) 동반, DIC(파종성 혈관내 응고) 유발 |
| M4Eo | 호산구 증가형 | inv(16) 유전적 이상, 예후 양호 |
장점:
- 현미경 관찰만으로 신속한 진단 가능
- 표준화된 프로토콜로 초기 치료 방향 설정 용이
한계:
- 유전적·분자적 정보 반영 부족
- 예후 예측력 낮음(생존율 차이를 설명하지 못함)
임상 사례:
- 45세 남성, 혈액검사에서 M2(FAB) 진단. 표준 화학요법 후 재발 → 유전자 검사에서 FLT3-ITD 변이 발견. WHO 분류 기준으로 고위험군 재분류.
2. WHO 분류 체계의 혁신과 주요 차이점
WHO(World Health Organization) 분류는 2001년 도입되어 유전적 변이를 중심으로 AML을 재정의했습니다. 2022년 개정판에서는 유전체 정보와 임상 데이터를 통합해 진단 정확도를 극대화했습니다.
▶ WHO 2022의 주요 변화
- Blast 기준 완화: AML 진단을 위한 골수/말초혈액 Blast 비율 **30% → 20%**로 하향.
- 유전적 아형 강조: t(8;21), inv(16), t(15;17) 등 특정 변이 존재 시 Blast 비율 무관하게 AML 진단.
- TP53 변이 독립 분류: 고위험군으로 지정해 치료 전략 차별화.
▶ WHO vs FAB 분류 비교
항목FABWHO
| 진단 기준 | 형태학 | 유전체+형태학+임상 |
| Blast 임계값 | 30% | 20% |
| 유전적 변이 | 무시 | 필수 포함 |
| 예후 예측 | 제한적 | 정밀(유리, 중간, 불량군 구분) |
예시:
- M3(FAB): WHO에선 AML with PML-RARA로 재분류. 비타민 A 유도분화 치료 가능.
- M4Eo(FAB): WHO에선 AML with inv(16)/CBFB-MYH11로 정의. 표적 치료 반응 우수.
3. 임상적 적용 사례와 예후 예측
▶ 사례 1: 유전적 변이에 따른 치료 차이
- 환자 프로필: 38세 여성, 골수 Blast 25%.
- FAB: M1(미성숙 골수세포 증가).
- WHO: NPM1 변이 확인 → "AML with mutated NPM1" 진단. 표준 치료 후 완전 관해.
- 의의: FAB는 유전적 정보 누락으로 인해 맞춤형 치료 계획 수립 불가.
▶ 사례 2: TP53 변이의 예후 영향
- 환자 프로필: 60세 남성, 골수 Blast 18%.
- FAB: MDS(골수이형성증후군).
- WHO: TP53 변이(VAF 45%) → "AML with TP53 mutation" 진단. 고위험군으로 판정, 면역치료 시행.
▶ 예후 예측 표
유전적 변이WHO 분류5년 생존율
| t(8;21) | 유리군 | 70~80% |
| FLT3-ITD | 중간군 | 40~50% |
| TP53 변이 | 불량군 | <10% |
최신 트렌드:
- ELN 2022 위험도 분류: 유전체 데이터 기반으로 치료 반응 예측.
- 액체 생검: 혈장 DNA 분석으로 재발 모니터링.
4. 최신 동향과 미래 전망: 정밀의학 시대의 분류 체계
▶ WHO 2022 vs ICC 2022 비교
**국제합의분류(ICC)**는 WHO보다 더 엄격한 기준을 적용합니다:
- TP53 변이: ICC는 VAF(변형 대립유전자 빈도) >10% 요구.
- CEBPA 변이: WHO는 Blast >20% 필요, ICC는 단일 변이도 인정.
분류 체계AML with TP53 mutationAML with CEBPA mutation
| WHO | Blast ≥20% + 변이 존재 | Blast ≥20% + 복합 변이 |
| ICC | VAF >10% + Blast ≥20% | 단일 변이 허용 |
▶ 인공지능(AI)과 다중오믹스
- 디지털 병리: AI 알고리즘으로 Blast 계수 및 핵 형태 자동 분석.
- NGS(차세대 염기서열분석): 500개 이상 유전자 패널로 변이 스크리닝.
- 예측 모델: 유전체 빅데이터 + 임상 정보 통합해 재발 위험 예측.
'혈핵학' 카테고리의 다른 글
| 혈핵학-재생불량성 빈혈(AA) vs 골수이형성증후군(MDS) 감별 포인트 (0) | 2025.05.13 |
|---|---|
| 혈핵학-혈우병 A/B형의 응고인자 결핍 메커니즘과 유전 상담 (0) | 2025.05.12 |
| 혈핵학-혈소판 기능 검사(PFA-100)의 원리와 임상 적용 (0) | 2025.05.12 |
| 혈핵학-만성 림프구성 백혈병(CLL)의 Rai/Binet 병기 분류 체계 (3) | 2025.05.12 |
| 혈핵학-전염단핵구증과 림프구 증식질환의 감별 진단 (0) | 2025.05.12 |
| 혈핵학-말초혈액 도말 검사를 통한 백혈구 이상 형태 식별법 (0) | 2025.05.12 |
| 혈핵학-자가면역 용혈성 빈혈에서 Coombs 검사의 역할과 한계 (0) | 2025.05.12 |
| 혈핵학-탈리세미아 진단을 위한 헤모글로빈 전기영동법 해석 가이드 (0) | 2025.05.11 |